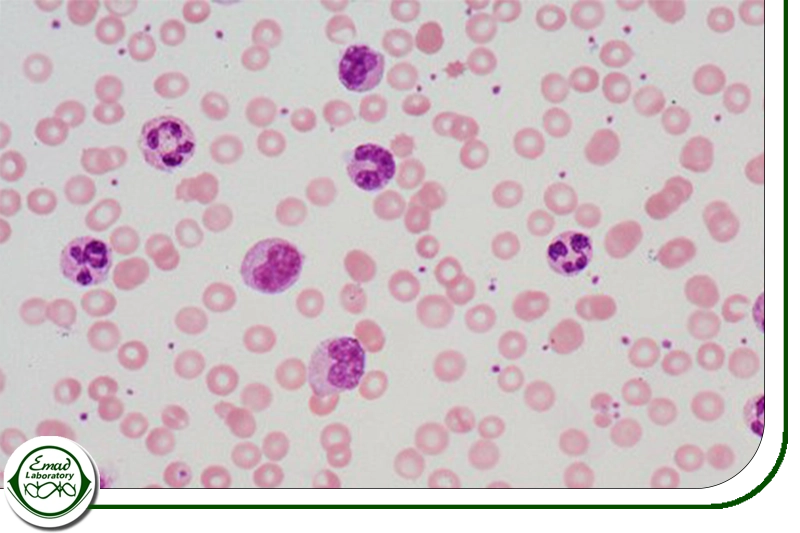
ارزیابی پاسخ به درمان

WBC یا گلبول های سفید خون (White Blood Cells) یکی از مهم ترین اجزای خون هستند که نقش حیاتی در سیستم ایمنی بدن ایفا می کنند. گلبول های سفید به مبارزه با عفونت ها، بیماری ها و عوامل خارجی مضر کمک می کنند. اندازه گیری تعداد گلبول های سفید خون یکی از آزمایش های اصلی خون (CBC) است که می تواند به تشخیص بسیاری از بیماری ها و وضعیت های بالینی کمک کند.

معرفی و طبقه بندی گلبول های سفید
گلبول های سفید خون یا لکوسیت ها سلول هایی هستند که جزو سیستم ایمنی بدن محسوب می شوند و به محافظت بدن در برابر بیماری ها و عوامل بیماری زا کمک می کنند. همه گلبول های سفید از سلول های بنیادی خاصی در مغز استخوان به نام سلول های بنیادی خونساز ساخته می شوند. این سلول ها در نقاط مختلف بدن مثل خون و سیستم لنفاوی حضور دارند. انواع مختلف گلبول های سفید شامل گرانولوسیت ها مثل نوتروفیل ها، ائوزینوفیل ها و بازوفیل ها، مونوسیت ها و لنفوسیت ها شامل سلول های T و سلول های B می باشد.
یکی از ویژگی های مهم گلبول های سفید این است که آن ها هسته دارند، برخلاف گلبول های قرمز که هسته ندارند. گلبول های سفید به دو دسته اصلی تقسیم می شوند: سلول های میلوئیدی و سلول های لنفوئیدی. سلول های میلوئیدی شامل نوتروفیل ها، ائوزینوفیل ها، بازوفیل ها، ماست سل ها و مونوسیت ها هستند. مونوسیت ها می توانند به سلول های دندریتیک و ماکروفاژ تبدیل شوند و برخی از این سلول ها توانایی بلعیدن میکروب ها و ذرات خارجی را دارند. سلول های لنفوئیدی شامل انواع مختلفی از سلول های T و B هستند که هر کدام نقش خاصی در سیستم ایمنی دارند، مثل کمک کردن به دیگر سلول ها یا تولید آنتی بادی.
نقش و اهمیت گلبول های سفید در سیستم ایمنی و تشخیص بیماری ها
گلبول های سفید در مغز استخوان تولید می شوند و وظیفه شان دفاع از بدن در برابر بیماری ها است. اندازه گیری تعداد گلبول های سفید یکی از بخش های مهم آزمایش خون است. وقتی تعداد گلبول های سفید در خون بیشتر از حد طبیعی شود، معمولاً نشانه وجود عفونت یا التهاب در بدن است. در برخی موارد هم ممکن است نشان دهنده بیماری های خاصی مثل سرطان خون یا مشکلات مغز استخوان باشد. گلبول های سفید تقریباً یک درصد از حجم کل خون را تشکیل می دهند و تعدادشان کمتر از گلبول های قرمز است. گلبول های سفید شامل چندین نوع مختلف هستند که هر کدام نقش خاصی در دفاع بدن ایفا می کنند. انواع اصلی گلبول های سفید عبارتند از:
نوتروفیل ها (Neutrophils)
نوتروفیل ها بیشترین تعداد گلبول های سفید را تشکیل می دهند و اولین خط دفاعی بدن در برابر عفونت های باکتریایی هستند. نوتروفیل ها در مغز استخوان ساخته می شوند و در جریان خون حرکت می کنند. وقتی جایی در بدن عفونت باکتریایی رخ می دهد، نوتروفیل ها از رگ های خونی به بافت آلوده مهاجرت کرده تا با باکتری ها مقابله کنند و آن ها را از بین ببرند
.وقتی بدن با یک عفونت جدی باکتریایی مواجه می شود، تعداد نوتروفیل ها افزایش می یابد و به همین دلیل تعداد کلی گلبول های سفید (WBC) بالاتر از حد طبیعی می شود. اما اگر تعداد کل گلبول های سفید خون کم باشد، ممکن است نوتروفیل های کافی برای مبارزه با عفونت های باکتریایی وجود نداشته باشد.
اهمیت شمارش نوتروفیل در تشخیص بیماری ها
نوتروفیل ها علاوه بر مبارزه با عفونت، به بهبود بافت های آسیب دیده هم کمک می کنند. میزان نوتروفیل ها در خون می تواند به دلایل مختلفی تغییر کند، از جمله عفونت ها، جراحات، مصرف داروها، برخی بیماری های ژنتیکی و استرس. اندازه گیری دقیق تعداد نوتروفیل ها (که به آن «شمارش مطلق نوتروفیل» گفته می شود) برای تشخیص عفونت، التهاب، سرطان خون و برخی بیماری های دیگر کاربرد دارد. هر چه تعداد نوتروفیل ها کمتر باشد، خطر ابتلا به عفونت بیشتر خواهد بود.

نوتروفیل ها به عنوان یکی از اجزای مهم گلبول های سفید، ارتباط نزدیکی با سایر پارامترهای آزمایش خون کامل (CBC) دارند. در بسیاری از بیماری ها، تغییرات نوتروفیل ها معمولاً همراه با تغییر در سایر سلول های خونی است. برای مثال، در یک عفونت باکتریایی شدید، علاوه بر افزایش نوتروفیل ها، ممکن است تعداد لنفوسیت ها کاهش و تعداد پلاکت ها افزایش یابد که این الگو به پزشک کمک می کند تا نوع بیماری را بهتر تشخیص دهد.
لنفوسیت ها (Lymphocytes)و نقش آن ها در سیستم ایمنی
لنفوسیت ها نوعی از گلبول های سفید خون هستند که نفوسیت ها در بافت های لنفاوی مثل طحال، غدد لنفاوی و غده تیموس ساخته می شوند. لنفوسیت ها حدود ۲۰ تا ۴۵ درصد از کل گلبول های سفید خون را تشکیل می دهند و بیشتر در اندام های لنفاوی ثانویه مثل طحال، گره های لنفاوی و بافت لنفاوی مرتبط با غشای مخاطی (که به آن MALT گفته می شود) ساکن هستند. این بافت ها در زیر غشای مخاطی بخش های مختلف بدن قرار دارند و نقش دفاعی دارند.
لنفوسیت ها نقش مهمی در مقابله با عوامل بیماری زا به ویژه ویروس ها دارند و آنتی بادی تولید می کنند تا بدن را در برابر این عوامل محافظت کنند. لنفوسیت ها مواد خارجی مثل ویروس ها و باکتری ها را شناسایی کرده و سلول ها یا آنتی بادی های خاصی را تولید می کنند که به طور مستقیم علیه این عوامل مبارزه می کنند. این فرآیند معمولاً چند روز تا چند هفته طول می کشد تا لنفوسیت ها بتوانند ماده خارجی جدید را شناسایی و علیه آن اقدام کنند.
لنفوسیت ها به دو دسته شامل سلول های B و T هستند که نقش حیاتی در پاسخ ایمنی تطبیقی دارند. لنفوسیت های B در مغز استخوان ساخته می شوند و مسئول تولید آنتی بادی ها هستند. لنفوسیت های T در تیموس (غده ای در قفسه سینه) شکل می گیرند و در شناسایی و نابودی سلول های عفونی و سرطانی نقش دارند. تیموس و مغز استخوان از اعضای اصلی سیستم لنفاوی هستند
اهمیت لنفوسیت ها در پاسخ ایمنی اکتسابی و تغییرات آن در بیماری ها
وظیفه اصلی لنفوسیت های B و T شناسایی و مقابله با عوامل بیماری زا است. این سلول ها بخشی از سیستم ایمنی اکتسابی هستند؛ یعنی سیستم ایمنی ای که طی سال ها و بر اثر تماس با عوامل مختلف محیطی شکل گرفته و تخصصی شده است. لنفوسیت ها به طور خاص روی آنتی ژن های خاصی (پروتئین هایی که روی سلول های بیگانه یا عوامل بیماری زا وجود دارند) تمرکز می کنند و علیه آن ها واکنش نشان می دهند. در بسیاری از بیماری های حاد، افزایش نوتروفیل ها همراه با کاهش لنفوسیت ها (که به آن لنفوپنی گفته می شود) دیده می شود. از طرف دیگر، در برخی عفونت های ویروسی هم ممکن است تعداد لنفوسیت ها افزایش یابد که به آن «لنفوسیتوز» گفته می شود.

مونوسیت ها (Monocytes)
مونوسیت ها نوعی از گلبول های سفید خون هستند که نقش مهمی در سیستم ایمنی بدن دارند. این سلول ها در مغز استخوان ساخته شده و سپس وارد جریان خون می شوند. . وقتی مونوسیت ها به بافت های آسیب دیده یا عفونی بدن می رسند قابلیت مهاجرت به بافت های بدن دارند و به ماکروفاژها تبدیل می شوند که در بلع و هضم پاتوژن ها و زباله های سلولی کمک می کنند. آن ها مثل سلول های نظافتچی بدن عمل می کنند؛ یعنی سلول های مرده و مواد زائد را می بلعند و از بین می برند. ماکروفاژها باکتری ها، سلول های مرده و دیگر ذرات زائد را می خورند و هضم می کنند. این فرایند را فاگوسیتوز می نامند که به معنی بلعیدن و هضم مواد زائد توسط سلول ها است.

در حالت طبیعی، مونوسیت ها حدود ۲ تا ۸ درصد از کل گلبول های سفید خون را تشکیل می دهند. معمولاً تعداد مونوسیت ها در آقایان کمی بیشتر از خانم ها است. تحقیقات نشان داده که تعداد مونوسیت ها در برخی نژادها مثل سیاه پوستان و آسیایی ها ممکن است کمی بیشتر باشد، اما این موضوع هنوز به طور کامل تایید نشده است.
ائوزینوفیل ها (Eosinophils)
ائوزینوفیل ها سلول های متحرک و فاگوسیتی هستند که از مغز استخوان منشأ می گیرند و به طور خاص در پاسخ به آلرژن ها و عفونت های انگلی فعال می شوند. ائوزینوفیل ها مدت کوتاهی در خون گردش می کنند و بیشتر در بافت هایی مثل ریه، تیموس، طحال و رحم ساکن می شوند. ائوزینوفیل ها علاوه بر تولید آنتی ژن و آزادسازی مواد مختلفی مانند پپتیدها، لیپیدها و سیتوکین ها، در ایجاد التهاب، آلرژی و بیماری هایی مانند برخی سرطان ها و بیماری های خودایمنی نقش دارند. این سلول ها حدود ۶ درصد از گلبول های سفید خون را تشکیل می دهند و در پاسخ به سیگنال های شیمیایی به محل های التهابی یا عفونی می روند؛ در آنجا با آزادسازی پروتئین های خاص، به تخریب انگل ها کمک می کنند.

ساختار ائوزینوفیل ها شامل هسته ای دو لوبی و گرانول هایی است که حاوی پروتئین های مثبت بار، آنزیم ها و واسطه های التهابی بوده و در عملکرد و آسیب به بافت ها نقش دارند. غشای پلاسمایی ائوزینوفیل ها گیرنده هایی برای تنظیم بلوغ و عملکرد سلولی دارد و فعالیت سلول با دگرانولاسیون تغییر می کند. افزایش تعداد این سلول ها در خون به حالتی به نام ائوزینوفیلی معروف است که می تواند نشان دهنده بیماری های مختلف باشد.
بازوفیل ها (Basophils)و نقش آن ها در واکنش های آلرژیک و سیستم ایمنی
بازوفیل ها نوعی گرانولوسیت غیرفاگوسیتی و کوچک ترین گلبول های سفید خون با هسته چندلوبی و گرانول های متاکروماتیک در سیتوپلاسم هستند که در پاسخ ایمنی بدن، به ویژه در واکنش های آلرژیک و التهابی نقش دارند و هیستامین و سایر مواد شیمیایی را آزاد می کنند که در پاسخ التهابی دخیل هستند. این سلول ها که تنها حدود ۵/۰ تا ۱ درصد از کل لکوسیت های خون را تشکیل می دهند، از مغز استخوان تولید شده و سپس وارد خون می شوند و در مواقع التهاب و پاسخ ایمنی تعدادشان ممکن است افزایش یابد.

بازوفیل ها با ماست سل ها شباهت دارند و هر دو گیرنده های IgE را روی سطح خود دارند و در واکنش های آلرژیک با آزادسازی هیستامین و دیگر واسطه های شیمیایی موجب گشاد شدن رگ های خونی، افزایش نفوذپذیری مویرگ ها و جذب سلول های ایمنی به محل التهاب می شوند. آن ها همچنین ماده ضدانعقادی به نام هپارین تولید می کنند که از لخته شدن خون جلوگیری می کند. افزایش بیش از حد بازوفیل ها (بازوفیلی) در خون می تواند نشان دهنده واکنش های التهابی، آلرژیک یا برخی بیماری ها باشد و معمولاً با آزمایش CBC اندازه گیری می شود. کمبود یا افزایش غیرطبیعی بازوفیل ها در سیستم ایمنی می تواند تعادل پاسخ ایمنی را تحت تأثیر قرار دهد.
اهمیت اندازه گیری WBC
آزمایش شمارش گلبول های سفید خون (WBC) یکی از آزمایش های مهم برای ارزیابی وضعیت سیستم ایمنی بدن است، به همین دلیل اندازه گیری تعداد گلبول های سفید خون (WBC count) یکی از ابزارهای مهم در تشخیص و پایش بسیاری از وضعیت های پزشکی است. هرگونه تغییر در تعداد گلبول های سفید خون می تواند نشان دهنده عفونت ها، بیماری های خودایمنی، التهاب ها یا مشکلات مغز استخوان باشد. این آزمایش به پزشکان کمک می کند تا تشخیص دقیق تری از بیماری ها داشته و درمان مناسبی را پیشنهاد دهند. معمولاً پزشک در مواردی مانند مشکوک بودن به لوسمی، وجود عفونت یا کم خونی (آنمی)، آزمایش گلبول های سفید خون یا WBC را تجویز می کند تا وضعیت سلول های سفید خون بررسی شود. در صورت مشاهده نتایج غیرطبیعی، مشورت با پزشک برای بررسی علت و تعیین درمان ضروری است. برخی از کاربردهای اصلی این آزمایش گلبول های سفید خون یا WBC عبارتند از:
تشخیص عفونت ها
افزایش تعداد گلبول های سفید معمولاً نشان دهنده وجود عفونت در بدن است. عفونت های باکتریایی، ویروسی و انگلی می توانند منجر به افزایش تعداد WBC شوند.
تشخیص بیماری های التهابی
افزایش تعداد WBC می تواند نشان دهنده وجود التهاب در بدن باشد. بیماری هایی مانند آرتریت روماتوئید و لوپوس می توانند باعث افزایش تعداد گلبول های سفید شوند.
پایش وضعیت های مزمن
در بیماری های مزمنی مانند لوسمی و سایر اختلالات خونی، تعداد گلبول های سفید ممکن است به طور غیرطبیعی افزایش یا کاهش یابد. اندازه گیری منظم WBC می تواند به پزشکان در ارزیابی و مدیریت این بیماری ها کمک کند.
ارزیابی پاسخ به درمان
در بیمارانی که تحت درمان های خاصی مانند شیمی درمانی قرار دارند، اندازه گیری تعداد WBC می تواند به ارزیابی اثربخشی درمان و شناسایی عوارض جانبی کمک کند.
مقادیر نرمال و غیرنرمال WBC
مقادیر نرمال WBC
مقادیر نرمال WBC در خون بسته به سن و جنسیت ممکن است متفاوت باشد، اما به طور کلی مقادیر نرمال به شرح زیر است:
- مقدار نرمال برای بزرگسالان به طور کل بین ۴۵۰۰ تا ۱۱۰۰۰ سلول در هر میکرولیتر خون (cells/µL) می باشد.
- مقدار نرمال برای کودکان ممکن است کمی بالاتر از بزرگسالان باشد.
مقادیر غیرنرمال
لکوپنی
لکوپنی (Leukopenia) با کاهش تعداد گلبول های سفید به کمتر از ۴۵۰۰ cells/µL توصیف می شود که این وضعیت می تواند نشان دهنده مشکلاتی مانند عفونت های شدید، اختلالات مغز استخوان، مصرف برخی داروها یا بیماری های خودایمنی باشد.
لکوسیتوز
لکوسیتوز (Leukocytosis) به افزایش تعداد گلبول های سفید به بالاتر از ۱۱۰۰۰ cells/µL گفته می شود که می تواند ناشی از عفونت ها، التهاب ها، استرس، مصرف داروها، یا برخی انواع سرطان ها باشد.
تفسیر نتایج WBC
اهمیت تفسیر بالینی نتایج آزمایش WBC در تشخیص بیماری ها
تفسیر آزمایش شمارش گلبول های سفید خون (WBC) بر اساس مقایسه نتایج با محدوده نرمال سن و شرایط فرد انجام می شود؛ افزایش یا کاهش تعداد این سلول ها می تواند نشان دهنده اختلالات خونی یا بیماری های مختلف باشد. پزشک برای تشخیص دقیق علت تغییرات WBC، علاوه بر نتایج آزمایش، داروهای مصرفی، علائم بالینی و سابقه پزشکی بیمار را نیز بررسی می کند.
کاهش تعداد گلبول های سفید معمولاً با علائمی مانند بدن درد، تب، لرز و سردرد همراه است، در حالی که افزایش تعداد آن اغلب بدون علامت بوده و بیشتر به بیماری های زمینه ای مرتبط است. بنابراین، تفسیر دقیق WBC باید در کنار سایر اطلاعات بالینی و آزمایشگاهی صورت گیرد تا بهترین تشخیص و درمان ممکن انجام شود. اگر علائمی از کاهش یا افزایش WBC مشاهده شد، پزشک معمولاً آزمایش شمارش گلبول های سفید را تجویز می کند.
عوامل مؤثر بر تغییرات شمارش گلبول های سفید در آزمایش خون
شرایط و عوامل متعددی می توانند روی نتایج آزمایش خون و شمارش گلبول های سفید خون مثلا نوتروفیل ها تأثیر بگذارند و برای تفسیر دقیق آزمایش، مهم است که پزشک از این موارد آگاه باشد. از جمله این عوامل می توان به وجود عفونت، دریافت شیمی درمانی یا پرتودرمانی، استفاده از کورتیکواستروئیدها مانند دگزامتازون، انجام جراحی های اخیر، استرس و اضطراب، بارداری و ابتلا به HIV اشاره کرد.

نتایج آزمایش نوتروفیل ممکن است بین آزمایشگاه ها متفاوت باشد و تحت تأثیر عواملی مانند سن، جنسیت، و بیماری های ارثی قرار گیرد. بنابراین، اطلاع دادن این موارد به پزشک قبل از انجام آزمایش، به تفسیر دقیق تر و تشخیص بهتر کمک می کند. در ادامه به برخی از تفسیرهای معمول نتایج WBC اشاره می کنیم:
افزایش نوتروفیل ها (نوتروفیلی)
نوتروفیل ها نوعی گلبول سفید هستند که نقش کلیدی در دفاع بدن در برابر عفونت ها دارند و افزایش تعداد آنها در خون که به آن «نوتروفیلیا» گفته می شود، معمولاً نشان دهنده پاسخ بدن به یک عفونت حاد، به ویژه عفونت باکتریایی است. علاوه بر عفونت، عوامل و شرایط مختلفی می توانند باعث افزایش نوتروفیل ها شوند، از جمله التهاب های غیرعفونی مانند آرتریت روماتوئید، جراحت یا عمل جراحی، استرس شدید، سیگار کشیدن یا استنشاق دود تنباکو، ورزش شدید، مصرف استروئیدها، حمله قلبی و برخی بیماری های مزمن مانند لوسمی میلوئیدی مزمن. همچنین در پاسخ به مصرف برخی از داروها و بیماری های مغز استخوان می توانند بر سطح نوتروفیل ها تأثیر بگذارند. بنابراین، افزایش نوتروفیل ممکن است نشانه عفونت باکتریایی، التهاب حاد یا استرس بدن باشد اما در مواردی می تواند به بیماری های جدی تری مانند سکته قلبی نیز اشاره کند که نیاز به بررسی و مشاوره پزشکی دارد.
افزایش لنفوسیت ها (لنفوسیتوز)
لنفوسیتوز به افزایش تعداد یا نسبت لنفوسیت ها گفته می شود. این افزایش معمولاً در پاسخ به عفونت های ویروسی مانند مونونوکلئوز عفونی، هپاتیت، عفونت های باکتریایی، بیماری های جدی تر مانند انواع اختلالات خونی (لنفوم و لوسمی لنفوئیدی) و بیماری های التهابی مزمن مانند آرتریت روماتوئید، یا واکنش به داروهای خاص رخ می دهد. در بزرگسالان، لنفوسیت ها بالاتر از ۵۰۰۰ در میکرولیتر، در کودکان بالاتر از ۷۰۰۰ میکرولیتر و در نوزادان بالاتر از ۹۰۰۰ در میکرولیتر خون به عنوان لنفوسیتوز تعریف می شود.
علل مختلفی باعث افزایش لنفوسیت ها می شوند که از جمله آن ها می توان به عفونت های ویروسی (مثل HIV، هپاتیت ها، و مونونوکلئوز)، بیماری های خونی (مانند لوسمی لنفوسیتی حاد و مزمن)، کم کاری تیروئید، و برداشتن طحال اشاره کرد. لنفوسیتوز می تواند به عنوان نشانه اولیه برخی سرطان ها نیز مطرح باشد و در نتیجه تشخیص و بررسی دقیق توسط پزشک بسیار مهم است.
افزایش مونوسیت ها (مونوسیتوز)
مونوسیت بالا در خون زمانی تشخیص داده می شود که درصد مونوسیت ها در میان گلبول های سفید بیشتر باشد. این وضعیت که به «مونوسیتوز» معروف است، می تواند ناشی از عوامل مختلفی از جمله عفونت های مزمن عفونی مانند سل، مالاریا و اندوکاردیت، بیماری های التهابی مزمن مثل التهاب روده، لوپوس و آرتریت روماتوئید، برخی انواع سرطان ها مانند لوسمی حاد میلوئیدی و لنفوم، و بیماری های خودایمنی باشد. اغلب افراد مبتلا به مونوسیتوز ممکن است هیچ علامتی نداشته باشند، اما در صورت بروز علائم، ممکن است شامل خستگی، ضعف، ورم و تب باشند که معمولاً مرتبط با علت زمینه ای افزایش مونوسیت ها است. عواملی مانند استرس حاد، اختلالات خونی، پاسخ ایمنی فعال، عفونت و التهاب می توانند باعث افزایش سطح مونوسیت در خون شوند. بنابراین، افزایش مونوسیت باید با توجه به شرایط بالینی و سایر آزمایش ها توسط پزشک بررسی شود.

افزایش ائوزینوفیل ها (ائوزینوفیلی)
بالا بودن سطح ائوزینوفیل در خون که به ائوزینوفیلی معروف است، به سه سطح خفیف (۱۵۰۰-۵۰۰ سلول در هر میکرولیتر)، متوسط (۵۰۰۰-۱۵۰۰ سلول در هر میکرولیتر) و شدید (بیش از ۵۰۰۰ سلول در هر میکرولیتر) تقسیم می شود. افزایش ائوزینوفیل ها معمولاً ناشی از شرایطی مانند عفونت های انگلی، واکنش های آلرژیک، آسم، اگزما، برخی اختلالات خونی (مانند لوسمی، سرطان سینه، کولورکتال، دهانه رحم، لنفوم هوچکین، تخمدان و پروستات)، بیماری های خودایمنی و سندرم هیپراِئوزینوفیلیک است. اگر تعداد ائوزینوفیل ها به طور مداوم بالا باشد، پزشک آزمایش های تکمیلی مانند بیوپسی یا تصویربرداری را برای تشخیص دقیق تر و درمان تجویز می کند. افزایش ائوزینوفیل ها می تواند در بیماری های مختلف مشاهده شود و معمولاً نیاز به بررسی دقیق تری دارد تا علت زمینه ای مشخص شود.
افزایش بازوفیل ها (بازوفیلی)
بازوفیل بالا در آزمایش خون که به بازوفیلیا معروف است، زمانی رخ می دهد که تعداد بازوفیل ها بیش از حد طبیعی افزایش یابد و معمولاً نشان دهنده التهاب مزمن، عفونت های ویروسی یا انگلی، واکنش های آلرژیک، برخی انواع سرطان های خونی، یا بیماری های التهابی مزمن مانند روماتیسم مفصلی و کولیت اولسراتیو است. همچنین مشکلات تیروئید مثل کم کاری یا پرکاری تیروئید می توانند باعث افزایش بازوفیل ها شوند. علائم بازوفیلی ممکن است شامل خارش و علائم واکنش آلرژیک (عطسه، آبریزش بینی، خارش چشم ها)، و علائم مربوط به بیماری زمینه ای مانند خستگی، تب، کاهش وزن، درد مفاصل یا مشکلات گوارشی باشد. پزشک با بررسی دقیق آزمایش خون و علائم بالینی، علت افزایش بازوفیل را تشخیص داده و درمان مناسب را تجویز می کند.
عوامل مؤثر بر تعداد WBC
چندین عامل می توانند بر تعداد گلبول های سفید خون تأثیر بگذارند. برخی از این عوامل عبارتند از:
عفونت ها
عفونت های حاد معمولاً باعث افزایش تعداد گلبول های سفید می شوند چون بدن برای مقابله با میکروب ها بیشتر این سلول ها را تولید می کند. همچنین، برخی عفونت های مزمن می توانند باعث کاهش تعداد WBC شوند.
التهاب ها
بیماری های التهابی مانند آرتریت روماتوئید، لوپوس، بیماری های التهابی روده (IBD) می توانند باعث افزایش تعداد گلبول های سفید شوند.
استرس
استرس فیزیکی یا روانی شدید می تواند موقتا تعداد WBC را افزایش دهد.
داروها
مصرف برخی داروها مانند کورتیکواستروئیدها، داروهای شیمی درمانی و برخی داروهای سرکوب کننده سیستم ایمنی می توانند تعداد WBC را تحت تاثیر قرار بدهند.
بیماری های خونی و مغز استخوان
اختلالات مغز استخوان (مانند سندروم میلودیسپلاستیک) و سرطان های خونی مانند لوسمی و لنفوما می توانند باعث تغییرات قابل توجهی در تعداد گلبول های سفید شوند.
نقص سیستم ایمنی
بیماری هایی مثل HIV که سیستم ایمنی را ضعیف می کنند معمولاً باعث کاهش تعداد گلبول های سفید می شوند.
 نقص سیستم ایمنی
نقص سیستم ایمنی
شرایط خاص و عوامل دیگر
- ترومای ناگهانی یا فشارهای شدید فیزیکی ممکن است روی تعداد WBC تأثیر بگذارند.
- رادیوتراپی و شیمی درمانی نیز به دلیل تأثیر مستقیم روی مغز استخوان، معمولاً باعث کاهش تعداد WBC می شوند.
کاهش تعداد WBC
برای کاهش تعداد گلبول های سفید و بهبود وضعیت سلامتی می توانید تغییرات مختلفی در سبک زندگی و رژیم غذایی خود ایجاد کنید. برخی از راهکارهای مؤثر عبارتند از:
رژیم غذایی سالم
مصرف غذاهای غنی از آنتی اکسیدان ها، ویتامین ها و مواد مغذی می تواند به بهبود سیستم ایمنی و تنظیم تعداد گلبول های سفید کمک کند. مواد غذایی مانند میوه ها، سبزیجات، ماهی و غلات کامل مفید هستند.
ورزش منظم
فعالیت بدنی منظم می تواند به بهبود عملکرد سیستم ایمنی و کاهش التهاب کمک کند.
مدیریت استرس
تکنیک های مدیریت استرس مانند مدیتیشن، یوگا و تمرینات تنفسی می توانند به کاهش استرس و تنظیم تعداد گلبول های سفید کمک کنند.
پرهیز از مواد مضر
اجتناب از مصرف دخانیات، الکل و مواد مخدر می تواند به بهبود سلامت کلی بدن و تنظیم تعداد گلبول های سفید کمک کند.

نتیجه گیری
اندازه گیری تعداد گلبول های سفید خون یکی از ابزارهای مهم در تشخیص و پایش بسیاری از وضعیت های پزشکی است. تعداد گلبول های سفید می تواند اطلاعات ارزشمندی درباره وضعیت سیستم ایمنی بدن، وجود عفونت ها، التهاب ها و سایر بیماری ها ارائه دهد. با درک بهتر از نقش و اهمیتWBC، می توانید به بهبود وضعیت سلامتی خود کمک کنید و در صورت نیاز به درمان مناسب تر و مؤثرتری دست یابید. همواره نتایج آزمایش های خود را با پزشک خود مطرح کرده و بر اساس راهنمایی های او عمل کنید.



بدون دیدگاه